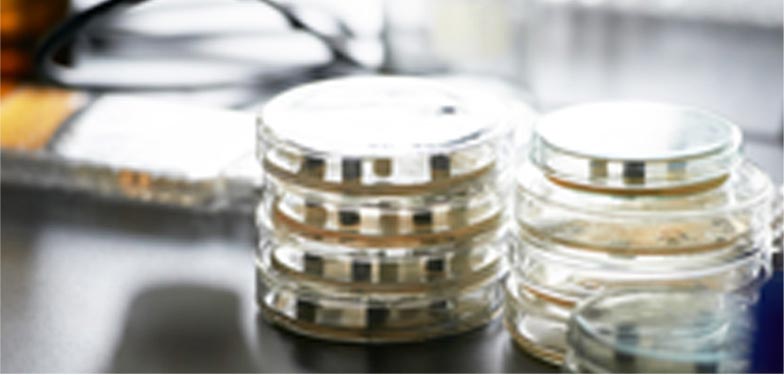

2011年8月�,經(jīng)科技部一年的嚴(yán)格審核�����,乳業(yè)生物技術(shù)國(guó)家重點(diǎn)實(shí)驗(yàn)室開始正式籌建,建造“金字塔”式高科技戰(zhàn)略版圖夢(mèng)想的光明乳業(yè)研究院也同日落成�����,意味著光明乳業(yè)的科研平臺(tái)和實(shí)力將提升至一個(gè)更高的水平���。2013年8月,經(jīng)行業(yè)專家現(xiàn)場(chǎng)考察和實(shí)驗(yàn)室建設(shè)運(yùn)行狀況�����,一致同意乳業(yè)生物技術(shù)國(guó)家重點(diǎn)實(shí)驗(yàn)室通過(guò)驗(yàn)收�,光明乳業(yè)擁有了國(guó)內(nèi)乳品行業(yè)唯一一家國(guó)家重點(diǎn)實(shí)驗(yàn)室。2018年6月��,依托光明乳業(yè)建設(shè)的“乳業(yè)生物技術(shù)國(guó)家重點(diǎn)實(shí)驗(yàn)室”���,被國(guó)家科技部評(píng)估為“優(yōu)秀類國(guó)家重點(diǎn)實(shí)驗(yàn)室”。獲得此至高殊榮����,意味著光明乳業(yè)科研實(shí)力在行業(yè)內(nèi)備受認(rèn)可,傲視群雄���。 2018年12月12日�����,光明乳業(yè)研究院榮獲2018年度國(guó)家技術(shù)發(fā)明獎(jiǎng),光明乳業(yè)是乳業(yè)行業(yè)中唯一一家榮獲2018年度國(guó)家技術(shù)發(fā)明獎(jiǎng)的企業(yè)����,這是光明乳業(yè)首次榮獲國(guó)家技術(shù)發(fā)明獎(jiǎng),也是第三次榮獲國(guó)家科學(xué)技術(shù)獎(jiǎng)����。
實(shí)驗(yàn)室自籌建以來(lái)�����,根據(jù)自身學(xué)科發(fā)展的優(yōu)勢(shì)和特色����,主持參與了一大批應(yīng)用基礎(chǔ)和關(guān)鍵技術(shù)攻關(guān)項(xiàng)目以及科技成果轉(zhuǎn)化型項(xiàng)目��。 先后主持和承擔(dān)了“973”�、“948”��、“863”、科技支撐計(jì)劃等國(guó)家和省部級(jí)課題50余項(xiàng)����。申請(qǐng)發(fā)明專利790項(xiàng),授權(quán)國(guó)際發(fā)明專利12項(xiàng)����,授權(quán)中國(guó)發(fā)明專利345項(xiàng)����,發(fā)表SCI文章180篇。主持制定國(guó)家標(biāo)準(zhǔn)2項(xiàng)�����,修訂國(guó)標(biāo)11項(xiàng),行業(yè)標(biāo)準(zhǔn)5項(xiàng)��,參與制定60余項(xiàng)。 2018年上半年���,光明乳業(yè)研究院申請(qǐng)國(guó)家專利12項(xiàng)���,其中9項(xiàng)發(fā)明����,3項(xiàng)實(shí)用新型。授權(quán)國(guó)家發(fā)明專利15項(xiàng)�,5項(xiàng)實(shí)用新型�����。授權(quán)國(guó)際專利授權(quán)1項(xiàng)�����。
實(shí)驗(yàn)室圍繞乳業(yè)生物技術(shù)領(lǐng)域基礎(chǔ)和應(yīng)用基礎(chǔ)性的國(guó)際研究前沿�����,根據(jù)我國(guó)乳品工業(yè)的發(fā)展需要�,遵照“有限目標(biāo)”和“有所為,有所不為”的精神��,確定在四個(gè)方面展開研究���,立足乳品與人體健康的相關(guān)性研究,逐步構(gòu)建乳品加工過(guò)程控制新理論與新方法體系��,從而達(dá)到控制乳品及配料的品質(zhì)�����,消除不安全因素,增進(jìn)人體健康��。實(shí)驗(yàn)室以下述四個(gè)方面為主要研究?jī)?nèi)容:(1)原料奶及乳制品質(zhì)量安全控制:圍繞牛奶中微生物污染的發(fā)生和傳播途徑及行為效應(yīng)����、牛奶加工過(guò)程化學(xué)危害物的產(chǎn)生和遷移變化規(guī)律與控制原理及乳品安全檢測(cè)新技術(shù)與新方法等方面展開研究。(2)新型乳品發(fā)酵劑理論與技術(shù):圍繞益生乳酸菌菌種的選育�����、發(fā)酵劑關(guān)鍵技術(shù)研究等方面展開研究。(3)功能性乳品研究與開發(fā):圍繞功能性乳品調(diào)節(jié)健康的作用機(jī)理�、牛乳組分和功能因子在加工中變化及相互作用機(jī)制�、牛乳組分變化對(duì)乳品品質(zhì)和人體健康的影響及功能性乳品設(shè)計(jì)基礎(chǔ)等方面開展研究。(4)新型干酪及其副產(chǎn)物綜合利用:著重進(jìn)行干酪產(chǎn)品研究與開發(fā)��、干酪加工副產(chǎn)物利用等方面展開研究����。
在乳制品研發(fā)方面��,研究院依托科技創(chuàng)新競(jìng)爭(zhēng)市場(chǎng)并領(lǐng)導(dǎo)著乳制品行業(yè)的潮流和發(fā)展,共累積推廣上市新產(chǎn)品150余種����,完成技術(shù)儲(chǔ)備項(xiàng)目200余項(xiàng),開發(fā)的莫斯利安常溫酸奶開創(chuàng)了國(guó)內(nèi)常溫酸奶品類��,產(chǎn)生了良好的經(jīng)濟(jì)效益和社會(huì)效益����。
 原料奶及乳制品質(zhì)量安全控制
原料奶及乳制品質(zhì)量安全控制

 新型乳品發(fā)酵劑理論與技術(shù)
新型乳品發(fā)酵劑理論與技術(shù)
功能性乳品理論與技術(shù)
功能性乳品理論與技術(shù)

 新型干酪及副產(chǎn)物理論與技術(shù)
新型干酪及副產(chǎn)物理論與技術(shù)

 網(wǎng)站導(dǎo)航
網(wǎng)站導(dǎo)航















 滬公網(wǎng)安備31011202012277號(hào)
滬公網(wǎng)安備31011202012277號(hào)